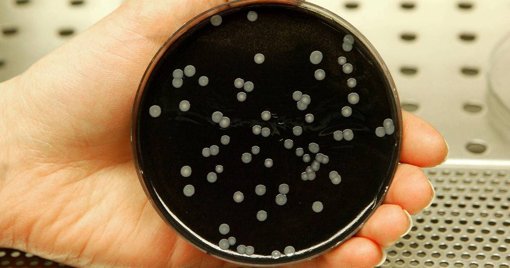
News Image

A Direção-Geral da Saúde (DGS) justifica o crescimento dos números com um "reforço do alerta clínico" e uma melhor notificação dos casos.
No entanto, a perspetiva de alguns médicos é mais cautelosa, apontando para possíveis falhas de controlo que podem estar a contribuir para a propagação da bactéria. A Doença dos Legionários é uma pneumonia grave causada pela inalação de aerossóis de água contaminada com a bactéria *Legionella pneumophila*, que prolifera em sistemas de água, torres de arrefecimento e sistemas de ar condicionado. Face a este cenário, as autoridades de saúde reforçam o apelo à população e às entidades responsáveis pela manutenção de edifícios para a necessidade de limpeza e desinfeção regular destes sistemas. A manutenção preventiva é considerada uma medida essencial para evitar a formação de focos da bactéria e prevenir novos surtos. O aumento de casos serve como um aviso para a importância da vigilância epidemiológica e da implementação rigorosa de protocolos de segurança em infraestruturas hídricas e de climatização, tanto em espaços públicos como privados.